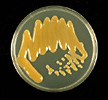

Updated 2005.
Citrus canker
Xanthomonas axonopodis pv.
citri and
Xanthomonas axonopodis pv.
aurantifolii
Numerous species, cultivars, and hybrids of citrus and citrus relatives including orange, grapefruit, pummelo, mandarin, lemon, lime, tangerine, tangelo, sour orange, rough lemon, calamondin, trifoliate orange, and kumquat.

Canker infected fruit, foliage, and stems.
(Courtesy T.R. Gottwald, copyright-free)
Symptoms and Signs
Citrus canker can be a serious disease where rainfall and warm temperatures are frequent during periods of shoot emergence and early fruit development. This is especially the case where tropical storms are prevalent. Citrus canker is mostly a leaf-spotting and fruit rind-blemishing disease, but when conditions are highly favorable for infection, infections cause defoliation (Figure 2), shoot dieback, and fruit drop.

Figure 2 |
Leaf Lesions: Citrus canker lesions start as pinpoint spots and attain a maximum size of 2 to 10 mm diameter (Figure 3). The eventual size of the lesions depends mainly on the age of the host tissue at the time of infection and on the citrus cultivar. Lesions become visible about 7 to 10 days after infection on the underside of leaves and soon thereafter on the upper surface. The young lesions are raised or ‘pustular’ on both surfaces of the leaf, but particularly on the lower leaf surface (Figure 4). The pustules eventually become corky and crateriform with a raised margin and sunken center. A characteristic symptom of the disease on leaves is the yellow halo that surrounds lesions (Figure 5). A more reliable diagnostic symptom of citrus canker is the water-soaked margin that develops around the necrotic tissue (Figure 6), which is easily detected with transmitted light.

Figure 3 |

Figure 4 |

Figure 5 |

Figure 6 |
Fruit and Stem Lesions: Citrus canker lesions on fruit (Figure 7) and stems (Figure 8) extend to 1 mm in depth, and are superficially similar to those on leaves. On fruit, the lesions can vary in size because the rind is susceptible for a longer time than for leaves and more than one infection cycle can occur (Figure 9). Infection of fruit may cause premature fruit drop but if the fruit remain on the tree until maturity such fruit have reduced fresh fruit marketability. Usually the internal quality of fruit is not affected, but occasionally individual lesions penetrate the rind deeply enough to expose the interior of the fruit to secondary infection by decay organisms (Figure 10). On stems, lesions can remain viable for several seasons. Thus, stem lesions can support long-term survival of the bacteria.

Figure 7 |

Figure 8 |

Figure 9 |

Figure 10 |
Leafminer Interaction: The Asian leafminer (Phyllocnistis citrella) can infest leaves, stems, and fruit and greatly increase the number of individual lesions which quickly coalesce and form large irregular shaped lesions that follow the outlines of the feeding galleries (Figure 11). Leafminers feed on the epidermis just below the leaf cuticle. Numerous cracks occur in the cuticle covering leafminer galleries providing means for bacteria to penetrate directly into the palisade parenchyma and spongy mesophyll which are highly susceptible to infection. Citrus foliar wounds normally callus within 1-2 days, however, the extensive wounds composed of the entire leafminer feeding galleries do not callus for 10-12 days, greatly extending the period of susceptibility of galleries to infection. Leafminer infestations can be very prevalent and severe producing hundreds if not thousands of potential infection courts on individual trees. When bacterial dispersal events occur in the presence of the leafminer, not only is inoculum production greatly exacerbated, but so is the potential for infection over the entire dispersal range.

Figure 11 |
Pathogen Biology
Causal Organism: The bacterium
Xanthomonas axonopodis pv. citri is a rod-shaped, gram-negative, and has a single polar flagellum. Colonies on laboratory media are usually yellow due to ‘xanthomonadin’ pigment production (Figure 12). When glucose or other sugars are added to the culture medium, colonies become very mucoid due to the production of an exopolysaccaride slime. A semi-selective medium can be prepared by adding an antibiotic, kasugamycin, which inhibits many contaminants but not xanthomonads. The maximum and optimum temperature ranges for growth are to 39°C (95 to 102°F) and 28 to 30°C (82 to 86°F), respectively.
Figure 12 |
Pathogen Confirmation: Serology, bacteriophage typing, fatty acid profiles, PCR (polymerase chain reaction), and DNA analysis are useful for identification and classification of bacterial isolates into pathovars. However, when such techniques are unavailable, strains of
X. axonopodis pv.
citri can be distinguished from other pathovars by a panel of susceptible and resistant citrus hosts. Bioassays can also be run on detached-leaves or leaf-disks (Figure 13). On detached leaves, lesions will be apparent 2 to 4 days after inoculation and different isolates can be tested side by side on the same leaf for comparison.

Figure 13 |
Host Susceptibility: In general, in field plantations, grapefruit (Figure 14), Mexican limes (Figure 15), and trifoliate orange (Figure 16) are highly susceptible to canker; sour orange, lemon (Figure 17), and sweet orange (Figure 18) are moderately susceptible; and mandarins (Figure 19) are moderately resistant. Within orange cultivars, early maturing cultivars are more susceptible than mid season cultivars which are in turn more susceptible than late season cultivars. However, when plant tissues are disrupted by wounds or by the feeding galleries of the Asian leafminer, internal leaf tissues (mesophyll) are exposed. When this occurs, all cultivars and most citrus relatives that express some level of field resistance can become infected (Figure 20).

Figure 14 |

Figure 15 |

Figure 16 |

Figure 17 |

Figure 18 |

Figure 19 |

Figure 20 |
Pathogen Diversity and Distribution: There are distinct forms of citrus canker disease caused by various pathovars and variants of the bacterium,
X. axonopodis. Because symptoms are generally similar, separation of these forms from each other is based on host range, cultural and physiological characteristics, bacteriophage sensitivity, serology, DNA-DNA homology, and by PCR (polymerase chain reaction) analysis of genomic DNA. The latter assays demonstrate that these forms are genetically unique.
The Asiatic form of canker (Canker A), caused by
X. axonopodis pv.
citri (syn.
Xanthomonas citri,
Xanthomonas campestris pv.
citri) is by far the most widespread and severe form of the disease.
Cancrosis B, caused by
X. axonopodis pv.
aurantifolii is a disease of lemons in Argentina, Paraguay, and Uruguay, but Mexican lime, sour orange, and pummelo are also susceptible (Figure 21). Cancrosis B isolates can be differentiated serologically from the Canker A, but not from Cancrosis C.
Cancrosis C, also caused by
X. axonopodis pv.
aurantifolii, was isolated from Mexican lime in Brazil. The only other known host for this bacterium is sour orange.
Other forms of canker bacteria have at times been reported. For example, Canker D, sometimes called citrus bacteriosis, was reported on Mexican lime in Mexico in 1981 but its existence remains controversial. Isolates were discovered in Oman, Saudi Arabia, Iran, and India that produce Canker A-like lesions only on Mexican lime (termed A* strains), and appear to be distinct serologically from all other known forms. Another atypical form of Canker A bacterium has been described from Reunion and surrounding islands in the Indian Ocean which has high levels of resistance to a number of antibiotics. Recently, a variant of Canker A, known as Canker Aw was discovered on the south east coastal areas of Florida. The Canker Aw isolate is distinct via PCR primer reaction and has a host range apparently restricted to Mexican lime and Alemow (Citrus macrophylla). Other as yet undescribed variants probably exist.
Disease Cycle and Epidemiology
 Disease Cycle
Disease Cycle Disease Cycle
Bacteria propagate in lesions in leaves, stems, and fruit. When there is free moisture on the lesions, the bacteria ooze out and can be dispersed to infect new growth. Wind-driven rain is the main dispersal agent and wind ≥ 8 m/s (18 mph) aids in the penetration of bacteria through the stomatal pores (Drawing of the disease cycle) or wounds made by thorns (Figure 20), insects (leafminer) (Figure 11), and blowing sand. Pruning causes severe wounding and can lead to infection. Multiplication of bacteria occurs mostly while the lesions are still expanding and numbers of bacteria produced per lesion is related to general host susceptibility (Figure 22 graph of growth).

Figure 20 |

Figure 11 |

Figure 22 |
The bacteria remain alive in the margins of the lesions in leaves and fruit until they abscise and fall to the ground. Bacteria have also been reported to survive in lesions on woody branches up to a few years of age (Figure 23). Bacteria that ooze onto plant surfaces do not survive and begin to die upon exposure to rapid drying. Death of bacteria is also accelerated by exposure to direct sunlight. Survival of exposed bacteria is limited to a few days in soil and to a few months in plant refuse that is incorporated into soil. On the other hand, the bacteria can survive for years in infected plant tissues that have been kept dry and free of soil.

Figure 23 |
Epidemiology
Infection: Leaves, stems, and fruit become resistant to infection as they mature unless they are wounded. Almost all infections occur on leaves and stems within the first 6 weeks after initiation of growth. The most critical period for fruit rind infection is during the first 90 days after petal fall. Any infection that occurs after this time results in the formation of only small and inconspicuous pustules. Because the fruit are susceptible over longer periods compared to leaves, infections can result from more than one dispersal event resulting in lesions of different age on the same fruit (Figure 8). Fruit can also act as an indicator of time of infection. Lesion age can be estimated on fruit and help determine when infection occurred and this information can be related to meteorological events, such as storms, that occurred at that time (Figure 24).

Figure 8 |

Figure 24 |
Pathogen Dispersal: Most spread of canker by wind and rain is for short distances, i.e., within trees or to neighboring trees. Canker develops more severely on the side of the tree exposed to wind-driven rain. Spread over longer distances, up to several miles, can result from severe meteorological events such as tropical storms, hurricanes, and tornadoes (Figure 25) (Figure 26). A recent study determined that 99% of infections that occur within a 30-day period are located within 594 m (1950 ft) of prior infected trees during normal weather conditions, i.e., when normal rain storms occur but tropical storms and hurricanes do not.. Hurricanes and tropical storms greatly increase citrus canker infection and can spread the bacteria over many miles. During 2004, Florida was subjected to three hurricanes that crossed and affected the majority of the commercial citrus industry. Bacterial dispersal gradients of up to 53 km (32 mi) were recorded and hundreds of new out breaks were subsequently discovered. However, long-distance spread more often occurs with the movement of diseased propagating material, such as budwood, rootstock seedlings, or budded trees. There is no record of seed transmission. Commercial shipments of diseased fruit are potentially a means of long-distance spread, but there is no authenticated record of this ever having happened. Nursery workers can carry bacteria from one nursery to another unless hands, clothes, and equipment are disinfected. Such spread can also result from contaminated budwood or contaminated budding equipment. Pruning, hedging (Figure 27), and spray equipment (Figure 28) have been demonstrated to spread the disease within and among plantings. Wooden harvesting boxes that contained diseased fruit and leaves and are later taken to disease-free orchards have also been implicated in long-distance spread (Figure 29).

Figure 25 |

Figure 26 |

Figure 27 |

Figure 28 |

Figure 29 |
Disease Management
Exclusion: The first line of defense against citrus canker is exclusion. Citrus canker still does not exist in some countries or regions of countries where climatic conditions are favorable for pathogen establishment, which is probably because of rigid restrictions on the importation of propagating material and fruit from areas with canker. Unfortunately, with increased international travel and trade, the likelihood of
X. axonopodis pv.
citri introduction is on the rise as it is with many exotic pests and pathogens. Documentations of 6 separate introductions of citrus canker into Florida have occurred since 1985, demonstrating that even with eradication, reintroduction is a continual process and problem.
Sanitation: Numerous cases of new infections of citrus canker are linked to human and mechanical transmission. Humans can carry bacteria on their skin, clothing, gloves, hand tools, picking sacks, ladders, etc. Vehicles can become contaminated by brushing wet foliage or coming in contact with plant material. Machinery such as tractors, implements, sprayers, hedgers, etc. can similarly become contaminated and even inadvertently transport plant parts. In areas where citrus canker is resident, it is necessary to construct decontamination stations for personnel, vehicles and machinery which are sprayed with bactericidal compounds (Figure 30).

Figure 30 |
Eradication: Once introduced into an area, elimination of inoculum by removal and destruction of infected and exposed trees is the most accepted form of eradication. To accomplish this, trees may be uprooted and burned (Figure 31) or in urban areas, cut down and chipped (Figure 32) and the refuse disposed of in a landfill. In Florida, state law requires that all citrus trees within 579 m (1900 ft) of infected trees must be removed in both residential and commercial situations.

Figure 31 |

Figure 32 |
Disease Management: In countries where the disease is well established and severe, only the more resistant types of citrus, such as Valencia oranges and mandarins may be profitable. In regions where canker is endemic, certain cultural practices are used to reduce the severity of the disease. It is imperative to avoid working in infected orchards when the trees are wet from dew or rain. The reduction of wind is another primary concern. Wind speeds are reduced by deployment of windbreaks on the perimeter of the orchard or between the rows (Figure 33) Reduction of wind speed lowers the probability of direct penetration of stomates by bacteria as well as entry of wind-induced injuries on foliage and fruit.

Figure 33 |
Where canker is a major problem, control requires integration of appropriate cultural practices including sanitation, windbreaks and leafminer control with frequent applications of copper sprays. Copper sprays have been shown to reduce infection somewhat. Because the fruit is susceptible to canker during the first 90 days after petal fall, it is important to maintain a protective coating of a copper material on the fruit surface during this period. Two or three treatments may be needed for this purpose, depending on rainfall and cultivar susceptibility. Windbreaks can greatly reduce spread and severity of disease and increase the efficacy of copper sprays. Leafminer control is particularly important on young trees and certain cultivars that have a high proportion and greater frequency of vegetative growth flushes.
Significance
History: Citrus canker probably originated in Southeast Asia, which is the ancestral home of citrus, but the disease continues to increase its geographic range in spite of the heightened regulations imposed by many countries to prevent introduction. Citrus canker presently occurs in over thirty countries in Asia, the Pacific and Indian Ocean islands, South America, and the U.S.
Citrus canker was first described after it was discovered in the U.S. in the Gulf States in 1915. However, canker lesions were noted on herbarium specimens collected in India as early as 1827. The Gulf States outbreak, which included 7 southern states, resulted from a shipment of infected trifoliate orange nursery stock from Japan. The disease also appeared earlier this century in South Africa and Australia. However, it was reportedly eliminated in these countries as well as the Gulf States through nursery and orchard inspections, quarantines, and the on-site burning of infected trees. Subsequent epidemics have occurred in Australia, Argentina, Uruguay, Brazil, Oman, Saudi Arabia, and Reunion Island. In some locations, eradication efforts have been attempted and failed. In others, active eradication campaigns continue ( Australia, Brazil, Florida).
Citrus canker was found in Florida in 13 locations from 1985 to 1992. Through extensive inspection and tree removal, eradication was believed to have been achieved. However, the disease reemerged in commercial plantations in Manatee County, Florida in June 1997 were eradication efforts had previously taken place. The age of the oldest lesions found indicated the disease had been in the area for about 1 to 1.5 years. This outbreak has largely been suppressed by destruction of several hundred acres of infected commercial citrus plantations.
A new and extensive outbreak was discovered in urban Miami, Florida in 1995. The original Miami outbreak consisted of approximately 14 square miles of infected residential properties when first discovered in September 1995, but had expanded to over 202 square miles as of December 1998 (Figure 34). The oldest lesions in the Miami area indicated that the disease had existed in that area for about 2 to 3 years prior to discovery. Severe tropical weather patterns have affected Miami in the past several years including hurricanes, tropical storms, tornadoes, and numerous rainstorms associated with high winds. These along with human movement have spread the infestation and greatly exacerbated the epidemic. At the time of this writing (September 2005), nearly all Florida counties within the commercial citrus range have had one or more outbreaks and about 10% of the commercial acreage has been removed in attempts to eradicate the disease (Figure 35).

Figure 34 |

Figure 35 |
Genomic analyses of bacterial isolates from the Miami and Manatee Co. areas have demonstrated significant differences between these isolates that suggest that the bacteria in the two areas were the result of two independent introductions. In July 1998, another outbreak was discovered in commercial citrus in Southwest Florida. Genomic analysis indicated that a bacterial isolate from this outbreak was identical to that found in Miami and therefore likely resulted from transport of inoculum or infected plant material from the Miami area.
Impact: Citrus canker is an extremely costly disease. Worldwide millions of dollars are spent annually on prevention, quarantines, eradication programs, and disease control. Undoubtedly, the most serious consequence of citrus canker infestations is the impact on commerce resulting from restrictions to interstate and international transport and sale of fruit originating from infested areas. The USDA, Animal and Plant Health Inspection Service in collaboration with the Florida Department of Agriculture and Consumer Services, Division of Plant Industry has formed a joint state/federal eradication campaign to eliminate the disease. An average of over 50 million dollars per year and over 600 personnel are presently dedicated to this program. In Florida alone, costs of running an eradication program from 1995 through 2005 plus compensation to commercial growers and homeowners for residential citrus destroyed is approaching $1 billion dollars.
Selected References
Bock, C.H., P.E. Parker, and T.R. Gottwald. 2005. The effect of simulated wind-driven rain on duration and distance of dispersal of
Xanthomonas axonopodis pv.
citri from canker infected citrus trees. Plant Dis. 89:71-80.
Cubero, J., J. H. Graham, T. Gottwald and T. Riley. 2000. Quantitative PCR method for the diagnosis of citrus bacterial canker. Applied and Environmental Microbiology 67:2849-2852.
Gottwald, T. R., J.H. Graham, and D. S. Egel. 1992. Analysis of foci of infection of Asiatic citrus canker in a Florida citrus orchard. Plant Dis. 76:389-396.
Gottwald, T. R., T. R. Graham, and T. S. Schubert. 1997. An epidemiological analysis of the spread of citrus canker in urban Miami, Florida, and synergistic interaction with the Asian citrus leafminer. Fruits 52:383-390.
Gottwald, T. R., J. H. Graham, and T. S. Schubert. 2002. Citrus Canker: The pathogen and its impact. Plant Health Progress DOI:10.1094/PHP-2002-0812-01-RV.
Gottwald, T. R., J. H. Graham, and T. S. Schubert. 2002. Citrus Canker: The pathogen and its impact. Plant Health Progress doi:10.1094/PHP-2002-0812-01-RV.
http://www.plantmanagementnet work.org/pub/php/review/citruscanker/
Gottwald, T. R., G. Hughes, J.H. Graham, X. Sun, and T. Riley. 2001. The citrus canker epidemic in Florida – the scientific basis of regulatory/eradication policy for an invasive plant pathogen. Phytopathology 91:30-34.
Gottwald, T. R., X. Sun, T. D. Riley, J. H. Graham, F. Ferrandino, and E. L. Taylor. 2001. Geo-Referenced, Spatiotemporal Analysis of the Urban Citrus Canker Epidemic in Florida. Phytopathology. 92:361-377.
Gottwald T. R and L. W. Timmer. 1994. The efficacy of windbreaks in reducing the spread of citrus canker caused by
Xanthomonas campestris pv. citri. Trop. Agric. 72:194-201.
Graham, J. H. and T. R. Gottwald. 1997. Research perspectives on eradication of citrus bacterial diseases in Florida. Plant Dis. 75:1193-1200
Graham, J. H., T. R. Gottwald, J. Cubero, and D. Achor. 2004. Xanthomonas axonopodus pv.
citri: Factors affecting successful eradication of citrus canker. Molecular Plant Pathology 5: 1-15.
Graham, J. H., T. R. Gottwald, T. D. Riley, and M. A. Bruce. 1992. Susceptibility of citrus fruit to bacterial spot and citrus canker. Phytopathology 82:452-457.
Leite Jr., R.P. and S.K. Mohan. 1990. Integrated management of citrus bacterial canker disease caused by
Xanthomonas campestris pv.
citri in the state of Paraná, Brazil. Crop Protection 9:3-7.
Reedy, B.C. 1984. Incidence of bacterial canker of citrus in relation to weather. Geobios New Reports 3:39-41.
Schubert, T.S., J. W. Miller, and D. W. Gabriel. 1996. Another outbreak of bacterial canker of citrus in Florida. Plant Dis. 80:1208.
Schubert, T. S., S. A. Rizivi, X. Sun, T. R. Gottwald, J. H. Graham, and W. N. Dixon. 2001. Meeting the challenge of eradicating citrus canker again in Florida. Plant Dis. 85: 340-356.
Stall, R. E. and E. L. Civerolo. 1991. Research relating to the recent outbreak of citrus canker in Florida. Annu. Rev. Phytopathol. 29:399-420.
Sun, X., R. E. Stall, J. Cubero, T. R. Gottwald, J. H. Graham, W. N. Dixon, T. S. Schubert, P. H. Chaloux, J. B. Jones, V. K. Stromberg, G. H. Lacy, B. D. Sutton. 2001. Detection and characterization of a new strain of citrus canker bacteria from key/Mexican lime and alemow in Florida. Plant Dis. 88:1179-1188.
Verniere, C. J., T. R. Gottwald, and O. Pruvost. 2002. Disease development and symptom expression of
Xanthomonas campestris pv.
citri in various citrus plant tissues. Phytopathology 93:832-843.
